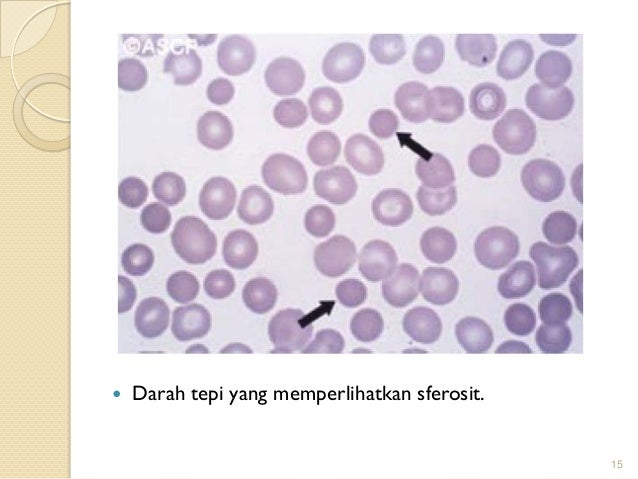

Ukuran Trombosit Yang Normal
Ukuran yang menjadi dasar penilaian sesuatu, ukuran yang diperlukan untuk pembuatan celana, ukuran trombosit yang normal, ukuran normal trombosit,








Random Image

Ukuran yang menjadi dasar penilaian sesuatu, ukuran yang diperlukan untuk pembuatan celana, ukuran trombosit yang normal, ukuran normal trombosit,